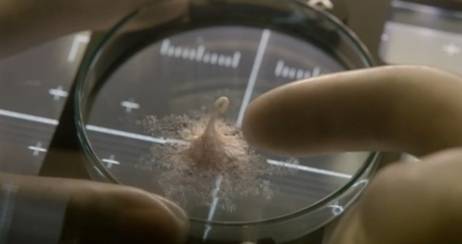

最近的高温已经严重到了人神共愤的地步,
感觉出门倒个垃圾都能热中暑。
前两天在天安门被热晕的非洲朋友表示:
在非洲都没热到中暑过,宝宝要回家!

好多宝宝都表示:
在这种天气里只能待在室内吹空调吃西瓜,
即使吹到头痛也只能忍着!

但小奇还有更加神奇的消暑神器,
那就是这部让你看完透心凉心飞扬的电影,
《异星觉醒》。

本片今年五月在国内上映,
看过的观众表示从电影院出来后冷汗直冒,
躺在床上瑟瑟发抖。

《异星觉醒》在故事情节上和《异形》系列很相似,
主题都是人类对未知生命的恐惧。
情节上也都是讲述了人类在太空遇到了外星生物,
而外星朋友却对人类大开杀戒,
从而营造出令人欲罢不能的恐惧感。

但不同的是,
《异形》主要营造了“在太空里
没人听得见你的尖叫”的太空密闭恐惧感,
在视觉上让人头皮发麻。
而《异星觉醒》则是直奔
“杀戮是生命求生的本能”的主旨,
从精神上让人彻底绝望。

而其卡司阵容也堪称梦幻级,
集齐了主演过《断背山》的
好莱坞著名影星杰克·吉伦哈尔,
“贱贱”的《死侍》扮演者瑞安·雷诺兹,
“谍女郎”丽贝卡·弗格森、
日本中年四天王之一的真田广之、
还有俄罗斯著名女星奥尔加·戴维克娜雅。
———我是即将开始吓人的分界线———
影片主要讲述了国际空间站的宇航员们
收到了来自火星的生物样本,
欣喜若狂带回空间站“抚养”,
并且取名为Kelvin卡尔文。
科学家为了唤醒这个看起来萌萌哒的生物,
对其进行电击。
而被唤醒的小卡尔文醒来第一件事
就是试图将和它亲密接触的科学家的手掰断,
暴露了其杀虐本性。

而这时宇航员们试图阻止它为时已晚,
高温、极寒、真空都无法阻挡已化身食人恶魔的卡尔文。
整个太空站变为它的屠宰场,
等待大家的只有挨个被残杀的命运。


而更加恐怖的是卡尔文不仅物理战斗力MAX,
智商也高到人类不是对手。
如果最后卡尔文随着太空船回到了地球,
等待人类的将是族灭。

万幸的是还带有一丝主角光环的大卫
(杰克· 吉伦哈尔饰)决定牺牲自己,
带着卡尔文永远留在太空,
留另一个幸存的女同事乘坐逃生舱回到地球通风报信。

但千算万算不如卡尔文一算!
不经过本宝宝同意就打算一起去太空同归于尽,
Too young too simple!
最后降落在东南亚的逃生舱:

除了节奏紧凑至极,
美工、特效、音效均为上乘之外,
本片最大的亮点就是堪称“神反转”的结局了。

最后到底发生了什么,
小奇在这里先卖个关子。
虽然观影过程能把人吓得浑身发抖,
但结局才是最冰冷的一盆冷水浇在心上,
让人从内而外感受到彻骨的凉意。
大热天的看这部电影,简直再合适不过。

《异形觉醒》今天已上线爱奇艺,
关掉空调,敢约吗?



评论